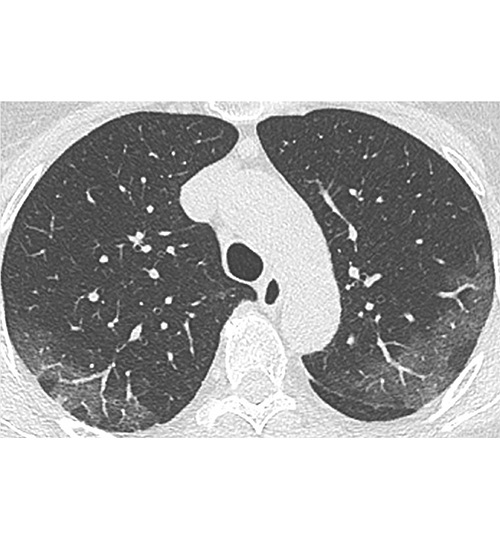

– Il n'y a pas de place pour la radiographie thoracique ! Si une imagerie est indiquée, il faut réaliser une tomodensitométrie (TDM).
– Chez des patients sans gravité clinique ni comorbidités, s’il y a une hésitation diagnostique entre pneumopathie bactérienne ou atteinte Covid-19, les arguments cliniques (foyer auscultatoire, douleur thoracique) et biologiques (hyperleucocytose) doivent prévaloir. En cas de fièvre résistant à l'antibiothérapie, il est préférable de demander une polymerase chain reaction (PCR) plutôt qu’une imagerie.
– Il n'y a actuellement pas d'indication à réaliser une TDM thoracique à des fins de dépistage chez des patients sans signes de gravité et sans comorbidités.
– La TDM thoracique sans injection en coupes fines n’est actuellement indiquée que chez les patients ayant un diagnostic suspecté ou confirmé de Covid-19 et des signes de gravité clinique (dyspnée, désaturation...) initiaux ou secondaires relevant d'une prise en charge hospitalière. Elle peut également se concevoir chez des patients suspects avec comorbidités, en attente des résultats de la PCR, ou en première ligne si les délais et la disponibilité de PCR deviennent limitants, ce qui semble se profiler.
– Chez les patients positifs pour le coronavirus en soins intensifs et réanimation, ayant une aggravation, la TDM doit rechercher une aggravation des lésions avec évolution vers un tableau de syndrome de détresse respiratoire aigu (SDRA), mais également un pneumothorax sous ventilation ou une complication thrombo-embolique, et doit donc être réalisée avec injection.
Quelles sont les aspects en TDM ?
Ce sont essentiellement des plages de verre dépoli non systématisées à prédominance sous-pleurale, et à un stade plus tardif de condensation alvéolaire. Il n'y a en règle pas d'excavations, de nodules ni de masses. Les micronodules bronchiolaires, les adénopathies médiastinales et les épanchements pleuraux sont rares, en sachant que ces derniers sont possibles en cas de décompensation cardiaque.
Ils sont illustrés à partir de ces quelques cas cliniques commentés : https://bit.ly/39NaivY
Dans tous les cas, le patient adressé vers un service de radiologie doit s’y présenter avec un masque chirurgical !
Alexandra Karsenty, La Revue du Praticien
Pour en savoir plus : Les recommandations de la Société française de radiologie dans un contexte de COVID-19